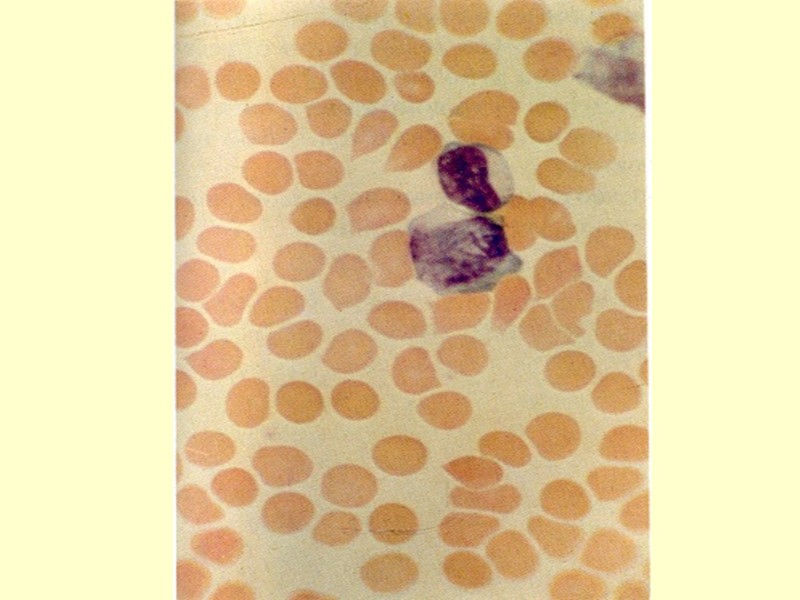

Лекция № 5 Тема: ДИФТЕРИЯ. Клиника, диагностика, принципы

33-lek_5_difteriya.ppt
- Количество слайдов: 40
Лекция № 5 Тема: ДИФТЕРИЯ. Клиника, диагностика, принципы лечения Лектор: проф., д. м. н., Каримов Искандер Загитович
ДИФТЕРИЯ Острое , антропонозное, инфекционное заболевание, вызываемое токсигенными штаммами C.diphtheriae, которое характеризуется воспалением в месте входных ворот с образованием фибринозной пленки и токсическим поражением сердечно-сосудистой и нервной систем. Diphtherion ( греч.) – пленка, перепонка. Историческая справка: 1828 г. – французский врач Бретано подробно описал клинические формы заболевания и дал им название «дифтерит». 1846 г. - Труссо А. обнаружил признаки дифтерии, как инфекционного заболевания и присвоил ему современное название «дифтерия»
2 1883 г. - Клебс Э.Т. в дифтеритических плёнках обнаружил возбудителя и описал его. 1884 г. - Леффлер Е. выделил возбудителя в чистом виде и описал его культуральные свойства. 1888 г. - Ру Е.П., Иерсен А.Э., Беринг Э.А. – выделили экзотоксин в чистом виде и получили антитоксин (начало специфической терапии дифтерии). 1923 г. - Глен и Рамон Г.получили анатоксин (начало массовой вакцинации против дифтерии). ЭТИОЛОГИЯ Corynеbacterium diphtheriae ( C.d.) - тонкие палочки с закругленными, утолщенными концами из-за скопления в них зерен волютина (полифосфата) ( coryne – булава) размером 1-12 на 0,3-0,8 мкм. Спор и капсул не имеют, Но на поверхности имеют фимбрии, облегчающие им адгезию.
3 Грам (+), полиморфны и по культуральным и ферментативным свойствам разделены на 3 биовара: GRAVIS, INTERMEDIUS, MITIS.Оптимальная температура для выращивания – 37 гр.С.Факультативные анаэробы. Устойчивы к низким температурам. При комнатной температуре, в воде, молоке выживают 1 – 3 недели. Дезинфектанты инактивируют С.d. в течение 1- 2 минут. При кипячении погибают мгновенно. Делятся «щелчкообразно» и поэтому 25-30% их в растущей культуре располагаются под углом друг к другу. Способностью к токсинообразованию обладают только лизогенные штаммы С.d. инфицированные в-фагом, имеющими ген-tox (кодирует структуру токсина). Любой биовар может продуцировать экзотоксин, ногенетически чаще gravis, реже всего mitis. Избыток железа в плазме усиливает токсинообразование !!
4 Экзотоксин С.d. ( полипептид) состоит из фракции А (собственно токсин) и фракции В ( распознает клетки-мишени и фиксирует фракцию А на ней (адгезия). Токсин в клетке ингибирует фактор элонгации 2 трансферазы, ответственной за наращивание (элонгацию) полипептидной цепи на рибосомах, что приводит к прекращению белкового синтеза в клетке и ее последующей постепенной гибели. Облегчает проникновение и усиливает действие токсина: гиалуронидаза, нейраминидаза, фибринолизин, гемолизин, некротизирующий и отечный факторы и др.Токсин в свободном состоянии в крови циркулирует 10 минут и 30 - 40 минут находится на поверхности клеток. После проникновения в клетку - антитоксном не связывется!!!
5 По силе действия занимает 3-е место среди биологичес-ких ядов !!! ( после ботулизма и столбняка ) ЭПИДЕМИОЛОГИЯ Источники инфекции : опасность инфицирования больной человек 3 1 реконвалесцент 2 2 бактерионоситель 1 3 эпидемиологическая опасность Санация реконвалесцентов завершается через 15 – 20 дней, но может затягиваться до 90 дней. Частота носительства в популяции составляет 1-10% Пути передачи - аэрогенный - реже контактный и пищевой
6 Учащение заболеваемости – в осенне-зимний период Периодичность подъема заболеваемости – 5-7 лет. Управляемая инфекция. Плановые прививки в детском возрасте привели к учащению заболеваний в настоящее время среди взрослых!!! ПАТОГЕНЕЗ 1. В месте внедрения ( слизистые или кожа) отмечается интенсивное размножение С.d.с продукцией экзоток- сина, что сопровождается гиперемией, отеком и веноз- ным стазом с усилением проницаемости подслизистых или подкожных мелких кровеносных сосудов 2. Выход фибриногена из капилляров, соприкосновение с тромбопластином поврежденных клеток слизистой и превращение в фибрин, который плотно удерживает
7 фибринозную пленку на поверхности слизистой. Утолщение и увеличение пленки до 5 – 6 дня болезни !!! 3. С.d. остаются под пленкой, но экзотоксин проникает в региональные лимфоузлы ( лимфаденит), подкожную клетчатку ( отек подкожной клетчатки) и кровь с фиксацией его на клетках-мишенях и последующим их токсико-аллергическим поражением: - сердце – миокард и проводящая система - нервная система – демиелинизация нервных волокон (парезы и параличи и поражение периферических симпатических узлов) - надпочечники – кровоизлияния в них, некроз ткани - почки – признаки нефроза
8 4. Корд-фактор С.d. (димиколат тригалозы), нарушающий дыхательные процессы в клетках, играет определенную роль в патогенезе дифтерии 5. Изменения в пораженных клетках обратимы и исчезают в сроки от 4-5 недель до 6-ти месяцев 6. После выздоровления формируется как антитоксичес- кий, так и антибактериальный иммунитет, но не пожизненный. Заболевание может повториться !!! КЛАССИФИКАЦИЯ ДИФТЕРИИ –учитывает: Локализацию процесса: - дифтерия ротоглотки А.36,0 - дифтерия другой лока- - дифтерия носоглотки А.36.1 лизации А.36. 8 - дифтерия гортани А.36.2 - дифтерия неуточнен- ная А.36.9 - дифтерия кожи А.36.3
9 2. Распространенность процесса: - локализованная - распространенная - комбинированная 3. Степень тяжести: - легкая - среднетяжелая - тяжелая - гипертоксическая 4. Характер местного воспаления: - катаральная - островчатая - пленчатая 5. Осложнения дифтерии (ИТШ.миокардит,неврит и т.д.)
10 Пример диагноза: Дифтерия ротоглотки, пленчатая, средней тяжести ( С.d. gravis,tox + ) ранний миокардит КЛИНИКА ДИФТЕРИИ ( инкубация 2 – 10 дней ) Носительство С.d. формируется после перенесенного заболевания (конвалесцентное ) или у здоровых лиц (1 - 10% в популяции ). Клинических проявлений не имеет, антитела против С.d. в крови не выявляются, подтверждается только бактериологически, обнаруже-нием в мазках С.d.!!! Оно может быть: - кратковременным - до 2 недель - средней продолжительности - 2 – 4 недели - затяжное - более 4 недель - хроническое - более 6 месяцев
11 СУБКЛИНИЧЕСКАКЯ ФОРМА ДИФТЕРИИ жалоб у больного нет гиперемия и незначительный отек миндалин и слизистой ротоглотки ( редко ) диагносцируется бактериологически, обнаружением С.d. в мазках и появлением антител против С.d. в крови может проявиться поздними осложнениями со стороны сердечно-сосудистой системы ( миокардит ) ДИФТЕРИЯ МИНДАЛИН И ГЛОТКИ Легкая форма заболевания: умеренная слабость при нормальной гемодинамике незначительная боль в горле, нормальная или субфебрильная температура тела гиперемия и отек миндалин и слизистой глотки наличие на миндалинах мелких пленок или небольшой сплошной пленки.
12 - увеличение и умеренная болезненность при пальпации подчелюстных лимфоузлов - по клиническим признакам врачами общей практики диагносцируется как тонзиллит, фарингит, ОРВЗ Средне-тяжелая форма дифтерии ротоглотки: острое начало, лихорадка до 38 – 38,5 гр.С, слабость, боль в мышцах и суставах, головная боль, снижение аппетита, жажда умеренная боль в горле при глотании бледные кожные покровы, иногда акроцианоз отек миндалин и слизистой ротоглотки, обнаружение фибринозной пленки со склонностью к распространению (иногда комбинированная форма) - увеличение и болезненность подчелюстных лимфо- узлов. Отек подкожной клетчатки шеи (до ключицы)
13 относительная тахикардия, склонность к гипотонии и снижению АКД, систолический шум на верхушке осложняется миокардитом, мононевритом ( чаще парез мягкого неба Тяжелая форма дифтерии ротоглотки: острое начало и высокая лихорадка, сильная головная боль, миалгии и артралгии, рвота, тревожный сон боль в горле ( может быть сильной), но чаще больные ощущают комок в горле и затрудненное дыхание бледность кожи в сочетании с цианозом глухие тоны сердца, тахикардия, затем – брадикардия ( плохой симптом) одышка при незначительной физической нагрузке увеличение и болезненность подчелюстных лимфоуз- лов, отек подкожной клетчатки шеи (ниже ключицы )
14 - фибринозная пленка на миндалинах с выходом за их пределы ( распространенная или комбинированная форма дифтерии) - затем одышка в покое, пароксизмальный тип дыхания (парез мышц диафрагмы) снижение АД, брадикардия, усиление гипоксии ( сердечная недостаточность и застой крови в легких) - появление геморрагического синдрома - поражение почек с развитием острой почечной недостаточности - развитие полиневритов к концу недели с нарушением двигательной и сенсорной функций и тяжелого миокардита
15 ГИПЕРТОКСИЧЕСКАЯ ФОРМА ДИФТЕРИИ: - возникает при массивной инфицирующей дозе С.d., обладающих чрезмерными токсинопродуцирующими возможностями - начинается как тяжелая форма дифтерии, но токсикоз всегда преобладает над местными воспалительными проявлениями - быстрое развитие ИТШ и ДВС чаще всего приводит к гибели больного на 2-ой – 3 день от начала болезни - фибринозная пленка на поверхности слизистой не успевает сформироваться !!! - диагноз чаще устанавливается посмертно по факту обнаружения С.d. бактериологическими методами !!!
16 ДИФТЕРИЯ ГОРТАНИ И ТРАХЕИ: Общетоксические проявления минимальные и ГИПОКСИЯ – ведущий синдром при этой форме заболе-вания из-за нарушения проходимости верхних дыхатель-ных путей вплоть до крупа, который в своем развитии проходит 3 стадии: КАТАРАЛЬНАЯ: ( длительность стадии 1 – 2 дня ) - жалобы на слабость, недомогание , субфебрильную температуру - присоединение кашля с мокротой, который быстро сменяется на «лающий» - осиплость голоса сохраняется и вне приступов кашля - при ларингоскопии – гиперемия и отек слизистых гор- тани, связок, трахеи ( пленок на слизистых еще нет !!)
17 СТЕНОТИЧЕСКАЯ: ( ЧАЩЕ НА 2 – 3 СУТКИ БОЛЕЗНИ ) - появление затрудненного и шумного дыхания - втяжение при вдохе надключичных и межреберных промежутков - афония и беззвучный кашель - больные беспокойны, испуганы, занимают вынуж- денное положение в постели, опираясь на руки - усиливается тахикардия, тахипное, снижается АКД, глухость тонов сердца, появляется цианоз кожи и слизистых - при ларингоскопии – отек, гиперемия с цианозом и крупозные пленки часто на большом протяжении - длительность этой стадии – 2 – 3 дня !!!
18 АСФИКТИЧЕСКАЯ ( продолжительность около 8 минут !!) - быстрое усиление дыхательной недостаточности - частое, поверхностное, шумное, аритмичное дыхание на фоне тотального цианоза, вынужденное положение - утрата вынужденного положения, спутанность а затем и утрата сознания, судороги и смерть ( без немедленной трахеостомии !!) ДИФТЕРИЯ НОСА: - может быть локализованной и распространенной - риноскопия выявляет - отек и гиперемию слизистой или наличие пленок на ней - интоксикация всегда выражена незначительно - всегда отмечается заложенность носа с серозными или серозно-геморрагическими выделениями из него
19 с обрывками пленок в них. - отек окологлазничной подкожной клетчатки (при переходе процесса в придаточные пазухи носа ) - риноскопия и положительный бактериологический тест- позволяют установить правильный диагноз - поздние осложнения при этой форме заболевания редкие !! ДИФТЕРИЯ ДРУГОЙ ЛОКАЛИЗАЦИИ ( глаза, кожа, половые органы и т.д.) – почти всегда вторичны и тяжесть течения обусловлена выраженностью первичного очага. Диагносцируется визуально ( эрозии кожи или слизистых с наличием фибринозной пленки) и бактериологически ( обнаружение в них С.d. )
20 ОСЛОЖНЕНИЯ - токсико-инфекционный шок, ДВС, мио-кардиты ( ранние и поздние ), полимиелорадикулонев-риты ( ранние и поздние) , токсический нефрозо-нефрит, гепатит ( только при тяжелых формах ), активация вторичной бактериальной флоры, асфиксия отторгнутой пленкой и т.д. ЛАБОРАТОРНАЯ ДИАГНОСТИКА: - микроскопия мазка из-под пленки (грам (+) бактерии расположенные под углом друг к другу) посевы мазков из-под пленки 3-х кратные до назначения антибиотиков !!! определение антител в крови до введения антитоксина и спустя 7-10 дней ( повышение не менее, чем в 4 раза) ОАК – умеренный нейтрофилез с токсической зерни- стостью, ускорение СОЭ, снижение эозинофилов
21 ОАМ – лейкоциты, эритроциты, высокая ОПМ ( содер- жание белка до 10 г/л ), цилиндры - Биохимические тесты – АСТ, ЛДГ,КОС, электролиты кро- ви, коагулограмма, почечные и печеночные ферменты - ( при поступлении всем !!) ЭКГ, консультации невролога, кардиолога и ЛОР ДИФФЕРЕНЦИАЛЬНАЯ ДИАГНОСТИКА: 1. Дифтерия ротоглотки: - стрептококковая и стафилококковая ангины - ангина Венсана - инфекционный мононуклеоз - скарлатина - паратонзиллярный инфильтрат или абсцесс - кандидоз ротоглотки
22 - ангина Людвига - ангинозно-бубонная форма туляремии - вторичная ангина при брюшном тифе, сифилисе, туберкулезе, неоплазме, лейкозе, агранулоцитозе, ожогах слизистой ротоглотки ( кислоты и щелочи), эпиглотите 2. Дифтерийный назофарингит: - менингококковый назофарингит - стрептококковый фарингит - аденовирусный фарингит 3 При дифтерии гортани: - ложный круп ( ОРВЗ, парагрипп, корь и т.д.) - асфиксия инородным телом - стрептококковый фарингит ( тяжелый )
23 ЛЕЧЕНИЕ Обязательная госпитализация и постельный режим (28 дней). Немедленное введение антитоксина: (в тысячах МЕ) В/В 40 80 120 160 легкие средне-тяжелые тяжелые гипертоксические В/М 60 110 160 220 Антиинфекционная терапия: - Benzylpenicillin 100-200 т.МЕ/кг/сутки в/м в 6 приемов - Ampicillin 50- 100 мг/кг/сутки в/м, в/н в 6 приемов - Amoxicillin 20 – 25 мг/кг/сутки в/н в 2 – 3 приема - Rifampicin 9 мг/кг/сутки в/н 1 раз ( мах. 600 мг ) - Clindamycin 10 – 25 мг/кг/сутки в/н в 4 приема - Eritromycin 20 – 30 мг/кг/сутки в/н в 4 приема
24 ПОДДЕРЖИВАЮЩАЯ ТЕРАПИЯ дезинтоксикация и достаточная гидратация, местное лечение. ингибиторы протеаз антиоксиданты диуретики глюкокортикоиды нестероидные противовоспалительные препараты антигистаминные препараты лечение миокардитов, невритов и т.д.
ПРОФИЛАКТИКА ( общая и специальная ) - общая : обследование контактных лиц, - заключительная дезинфекция в очаге, - установление в очаге карантина на 7 дней специальная: введения дифтерийного АНАТОКСИНА. первоначальная иммунизация на 3,4,5 месяцах жизни. ревакцинация в 18 месяцев, а затем в 6, 11, 14, 18 лет. взрослое население подлежит ревакцинации каждые 10 лет.

